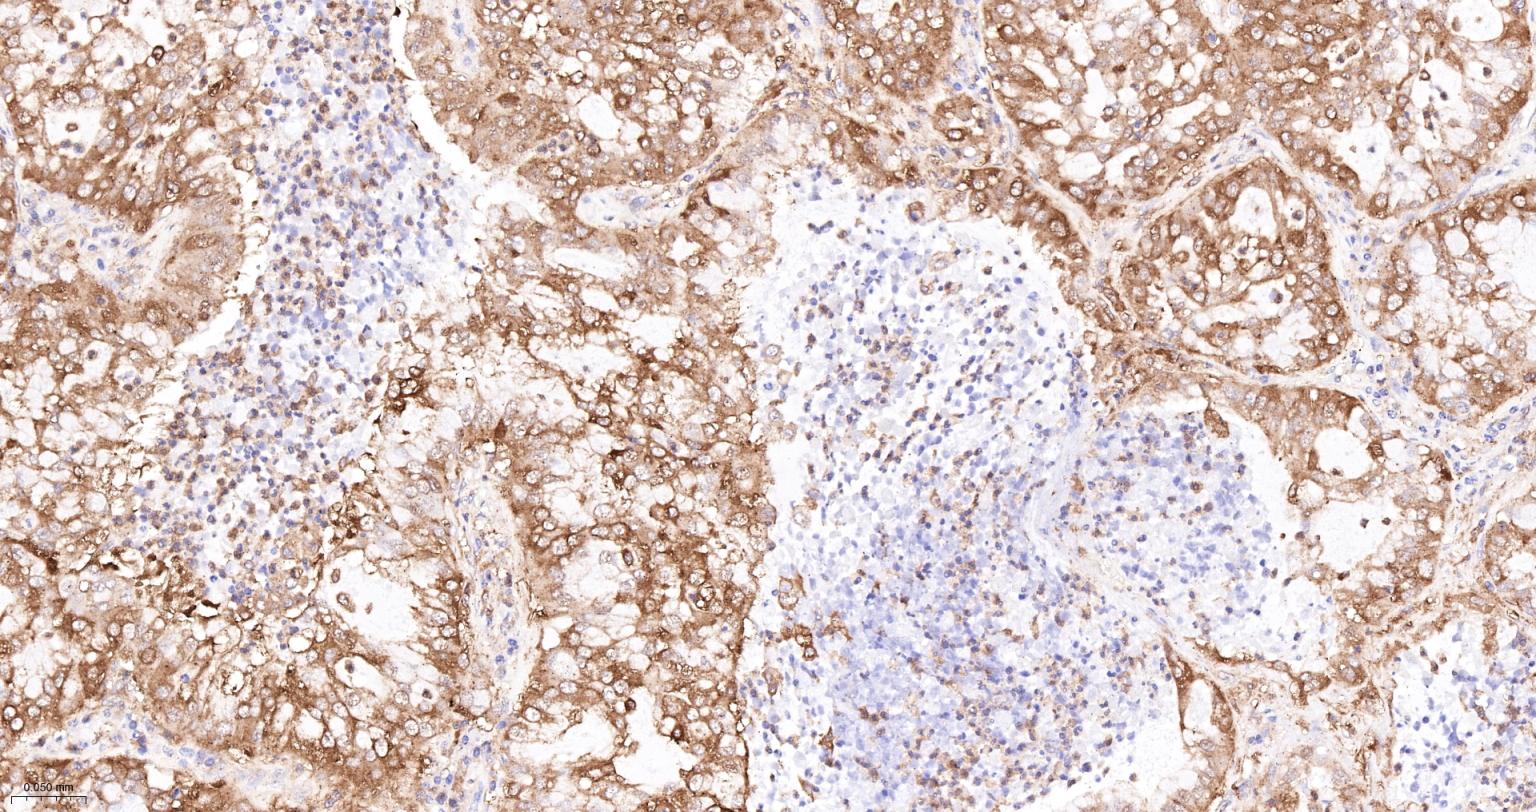
丙酮酸激酶M2重组兔单抗

PKM2 Recombinant Rabbit mAb (一抗) - WB,IHC-P,IHC-F,IF,Flow-Cyt,ICC/IF | Bioss
Rrmab?兔单抗

货号:bsm-61301R
产品详情
相关标记
相关产品
相关文献
常见问题
概述
产品编号
bsm-61301R
产品类型
重组兔单抗、mIHC精品抗体
英文名称
PKM2 Recombinant Rabbit mAb
中文名称
丙酮酸激酶M2重组兔单抗
英文别名
CTHBP; HEL-S-30; OIP3; PK3; PKM2; TCB; THBP1; p58; Pk-2; Pk-3; PK; PKM12; KPYM_HUMAN; PKM; Cytosolic thyroid hormone-binding protein (CTHBP); Opa-interacting protein 3 (OIP-3); Pyruvate kinase 2/3; Pyruvate kinase muscle isozyme; Threonine-protein kinase PKM2; Thyroid hormone-binding protein 1 (THBP1); Tumor M2-PK; Tyrosine-protein kinase PKM2; 2.7.1.40; PK2; KPYM_MOUSE; Pykm; KPYM_RAT; pyruvate kinase M1/2; pyruvate kinase, muscle
抗体来源
Rabbit
免疫原
A synthesized peptide derived from human PKM: 50-100
亚型
IgG
性状
Liquid
纯化方法
affinity purified by Protein A
克隆类型
Recombinant
克隆号
9H2
理论分子量
58 kDa
检测分子量
60 kDa
储存液
10mM phosphate buffered saline(pH 7.4) with 150mM sodium chloride, 0.05% BSA, 0.02% Proclin300 and 50% glycerol.
研究领域
Cancer > Cancer Metabolism > Metabolic signaling pathway > Metabolism of carbohydrates
Cancer > Tumor biomarkers > Enzymes
Epigenetics and Nuclear Signaling > Cell cycle > Kinases/Phosphatases
Metabolism > Pathways and Processes > Metabolic signaling pathways > Carbohydrate metabolism
Metabolism > Pathways and Processes > Metabolic signaling pathways > Energy transfer pathways > Energy Metabolism
SWISS
Gene ID
保存条件
Store at 4℃ for short term. Store at -20℃ for long term. Avoid repeated freeze/thaw cycles.
注意事项
This product as supplied is intended for research use only, not for use in human, therapeutic or diagnostic applications.
数据库链接
产品介绍
丙酮酸激酶(PK)有L、R、M1、M2四种同功酶,均为四聚体。
L型主要分布于肝脏,R型存在于红细胞,在结构、免疫学和动力学上十分相似,由同一基因调控;M1存在于肌肉中,M2分布于除上述以外的其他组织(尤以肾脏最多)以及胎儿各组织。PK也是一种癌胚蛋白,在恶性肿瘤中,增高的都是M2型。
背景资料
Catalyzes the final rate-limiting step of glycolysis by mediating the transfer of a phosphoryl group from phosphoenolpyruvate (PEP) to ADP, generating ATP. The ratio between the highly active tetrameric form and nearly inactive dimeric form determines whether glucose carbons are channeled to biosynthetic processes or used for glycolytic ATP production.

产品应用
| 应用 | 已检合格种属 | 预测种属 | 推荐稀释比例 |
|---|---|---|---|
| WB | Human, Mouse, Rat | 1:1000-2000 | |
| IHC-P | Human | Mouse, Rat | 1:100-500 |
| IHC-F | Human | Mouse, Rat | 1:100-500 |
| IF | Human | Mouse, Rat | 1:100-500 |
| Flow-Cyt | Human | Mouse, Rat | 1:50-100 |
| ICC/IF | Human, Mouse, Rat | 1:50-200 |
交叉反应
交叉反应: Human, Mouse, Rat
相关产品
暂无相关产品
靶标
基因名
PKM
蛋白名
Pyruvate kinase PKM
亚基
Monomer and homotetramer. Exists as a monomer in the absence of FBP, and reversibly associates to form a homotetramer in the presence of FBP. The monomeric form binds T3. Tetramer formation induces pyruvate kinase activity. The tetrameric form has high affinity for the substrate and is associated within the glycolytic enzyme complex. Exists in a nearly inactive dimeric form in tumor cells and the dimeric form has less affinity for the substrate. Binding to certain oncoproteins such as HPV-16 E7 oncoprotein can trigger dimerization. FBP stimulates the formation of tetramers from dimers. Interacts with HERC1, POU5F1 and PML. Interacts (isoform M2) with EGLN3; the interaction hydroxylates PKM under hypoxia and enhances binding to HIF1A. Interacts (isoform M2) with HIF1A; the interaction is enhanced by binding of EGLN3, promoting enhanced transcription activity under hypoxia.
亚细胞定位
Cytoplasm. Nucleus. Note=Translocates to the nucleus in response to different apoptotic stimuli. Nuclear translocation is sufficient to induce cell death that is caspase independent, isoform-specific and independent of its enzymatic activity.
组织特异性
Specifically expressed in proliferating cells, such as embryonic stem cells, embryonic carcinoma cells, as well as cancer cells.
翻译后修饰
ISGylated.
Under hypoxia, hydroxylated by EGLN3.
Acetylation at Lys-305 is stimulated by high glucose concentration, it decreases enzyme activity and promotes its lysosomal-dependent degradation via chaperone-mediated autophagy.
Under hypoxia, hydroxylated by EGLN3.
Acetylation at Lys-305 is stimulated by high glucose concentration, it decreases enzyme activity and promotes its lysosomal-dependent degradation via chaperone-mediated autophagy.
相似性
Belongs to the pyruvate kinase family.
功能
Glycolytic enzyme that catalyzes the transfer of a phosphoryl group from phosphoenolpyruvate (PEP) to ADP, generating ATP. Stimulates POU5F1-mediated transcriptional activation. Plays a general role in caspase independent cell death of tumor cells. The ratio betwween the highly active tetrameric form and nearly inactive dimeric form determines whether glucose carbons are channeled to biosynthetic processes or used for glycolytic ATP production. The transition between the 2 forms contributes to the control of glycolysis and is important for tumor cell proliferation and survival.
同靶标产品
相关文献
提示: 发表研究结果有使用 bsm-61301R 时请让我们知道,以便我们可以引用参考文章。作为回馈,资料提供者将获得我们送上的小礼品。